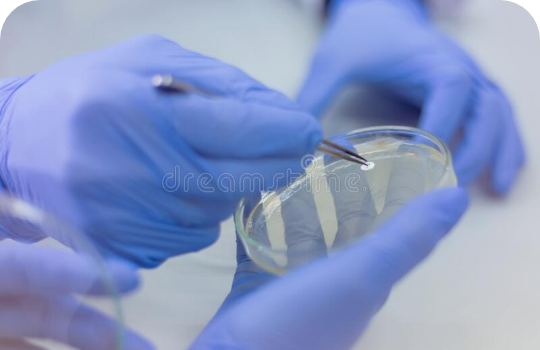
Services logo

Established in 2004, CIDP (Centre International de Développement Pharmaceutique) is an international Contract Research Organisation (CRO) that carries out high R&D activities for pharmaceutical, medical device, nutraceutical and cosmetic industries.
What is EX Vivo?
Incorporated in 2004 in Mauritius, the CIDP head office occupies today an area of 2000 m² with specially designed facilities for research and clinical activities as well as for all support functions (Data Management, Biostatistics, administrative areas…)
Sensitisation
Metabolism
Sensitisation
MetabolismAdvantages of ex vivo
Incorporated in 2004 in Mauritius, the CIDP head office occupies today an area of 2000 m² with specially designed facilities for research and clinical activities as well as for all support functions (Data Management, Biostatistics, administrative areas…)
Our Models
Incorporated in 2004 in Mauritius, the CIDP head office occupies today an area of 2000 m² with specially designed facilities.